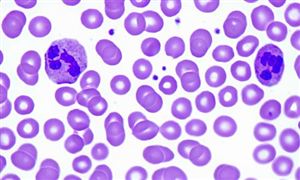

抗病毒药行业现状洞察与未来趋势分析
- 抗病毒药行业发展机遇大,如何驱动行业内在发展动力?
-




图片来源于网络,如有侵权,请联系删除免费提问专家- 北京用户提问:市场竞争激烈,外来强手加大布局,国内主题公园如何突围?
- 上海用户提问:智能船舶发展行动计划发布,船舶制造企业的机
- 江苏用户提问:研发水平落后,低端产品比例大,医药企业如何实现转型?
- 广东用户提问:中国海洋经济走出去的新路径在哪?该如何去制定长远规划?
- 福建用户提问:5G牌照发放,产业加快布局,通信设备企业的投资机会在哪里?
- 四川用户提问:行业集中度不断提高,云计算企业如何准确把握行业投资机会?
- 河南用户提问:节能环保资金缺乏,企业承受能力有限,电力企业如何突破瓶颈?
- 浙江用户提问:细分领域差异化突出,互联网金融企业如何把握最佳机遇?
- 湖北用户提问:汽车工业转型,能源结构调整,新能源汽车发展机遇在哪里?
- 江西用户提问:稀土行业发展现状如何,怎么推动稀土产业高质量发展?
抗病毒药行业现状洞察与未来趋势分析
在全球公共卫生安全格局深刻调整的背景下,抗病毒药物研发面临三重核心矛盾:病毒变异速度超越药物研发周期、急性自限性病毒削弱企业研发动力、市场需求爆发性与供应链脆弱性并存。中研普华产业院研究报告《2024-2029年抗病毒药行业风险投资态势及投融资策略指引报告》指出,这种矛盾在新冠肺炎疫情期间集中爆发,暴露出全球抗病毒药物储备不足、创新药物可及性低等深层次问题。

图片来源于网络,如有侵权,请联系删除
一、行业现状:结构性变革中的机遇与挑战

图片来源于网络,如有侵权,请联系删除
(一)政策驱动下的生态重构
中国政府通过"医保目录动态调整+审批流程优化+产学研协同"的政策组合拳,推动行业从低水平重复向高质量创新转型。医保目录将比克恩丙诺片等创新药物纳入报销范围,广东省将HIV治疗报销比例提升至90%,直接减轻患者经济负担。药品审批流程的优化使创新药上市周期大幅缩短。
政策红利加速转化为行业动能,但区域发展不均衡问题依然突出。中研普华数据显示,东部地区抗病毒药物市场规模占全国六成以上,而中西部地区基层医疗可及性不足。这种分化要求政策设计需兼顾效率与公平,通过医疗资源下沉实现普惠供给。
(二)技术革命引领研发范式转变
基因编辑技术(CRISPR/Cas9)、纳米递送系统、人工智能算法的突破,正在重塑抗病毒药物研发体系。辉瑞公司利用AI平台优化新冠口服药Paxlovid分子结构,显著提升抑制病毒蛋白酶活性。基因测序技术使企业能够针对特定病毒株开发定向产品,例如利用CRISPR-Cas13系统靶向降解病毒RNA,实现广谱抗病毒突破。
技术突破仍面临病毒变异速度快、耐药性机制复杂等挑战。中研普华强调,企业需建立"多靶点、多机制"的研发策略,通过RNA干扰+免疫调节双机制设计,提高抗病毒谱广度。这种技术路径的转变,正在推动行业从经验驱动向数据驱动转型。
(三)市场格局的多元化演变
全球抗病毒药物市场呈现"头部垄断与细分突破并存"的特征。在HIV领域,吉利德、GSK通过专利布局形成寡头垄断;在流感领域,东阳光药、罗氏凭借奥司他韦产能与品牌优势占据主导。国产企业通过"仿创结合"策略突破重围,前沿生物的艾博韦泰成为首个国产长效HIV融合抑制剂。
市场竞争焦点正从产品竞争转向生态竞争。领先企业通过"药品+健康管理"一体化解决方案构建壁垒,例如推出抗病毒口服液+健康课程订阅服务,结合可穿戴设备实现病毒载量实时监测与用药推荐。这种服务模式的创新,正在重新定义抗病毒药物的价值边界。
(四)供应链的韧性挑战
上游原材料质量与供应稳定性直接影响药物研发进程。云南、广西等地的中药材种植基地通过"订单农业"模式,确保板蓝根、三七等抗病毒药材年产能达十万吨。中游生产环节,智能化生产线普及率超七成,区块链溯源系统覆盖头部企业,消费者扫码即可查看药材来源与检测报告。
供应链智能化改造成为应对需求波动的关键。某企业利用AI算法分析流感监测数据,提前调整生产计划,避免缺货或积压。柔性生产技术实现小批量、多品种定制化生产,满足细分市场需求。这种供应链的敏捷化转型,正在提升行业抗风险能力。
二、发展趋势:技术驱动与市场重构的双重变革
(一)技术创新:从被动防御到主动进攻
未来五年,基因疗法、细胞疗法、AI制药将成为三大技术方向。CAR-T细胞疗法在HIV功能性治愈中的探索,标志着免疫治疗从辅助手段向核心疗法跃迁。人工智能通过深度学习模型预测病毒变异趋势,指导药物设计,将新药研发周期大幅缩短。
广谱抗病毒药物的研发是技术突破的重点领域。默沙东的莫努匹拉韦因对多种RNA病毒有效,被视为"泛冠状病毒药物"的潜在候选。中研普华产业院研究报告《2024-2029年抗病毒药行业风险投资态势及投融资策略指引报告》预测,基因编辑与AI技术的融合将催生下一代研发平台,通过构建"病毒-宿主-药物"交互模型,实现精准药物设计与个性化治疗方案。
(二)市场拓展:新兴市场与细分领域的双轮驱动
亚太、拉美、非洲等新兴市场将成为增长核心引擎。中国凭借医保覆盖扩大与基层医疗网络完善,有望成为全球最大抗病毒药物消费市场之一。针对耐药菌、新发病毒的特效药研发,以及HIV暴露前预防用药(PrEP)的普及,将拓展市场边界。
细分市场呈现"专业化+个性化"特征。针对儿童群体的颗粒剂型口服液通过改善口感提升依从性,针对老年群体的免疫增强型产品结合营养补充功能。宠物经济兴起带动犬猫专用抗病毒产品需求激增,成为新的增长点。这种市场细分趋势,要求企业具备更强的需求洞察与产品创新能力。
(三)政策协同:创新激励与质量监管的平衡艺术
未来政策将围绕"创新激励、质量监管、国际合作"三大主线构建支持体系。通过税收优惠、研发补贴、专利延长等措施降低企业创新成本,同时建立全生命周期质量追溯体系,强化原料药、中间体等上游环节的合规性。
国际合作政策推动跨国多中心临床试验与数据共享,加速全球新药同步上市。参与国际标准制定(如WHO抗病毒药物指南)成为企业提升竞争力的重要途径。政策协同需平衡鼓励创新与保障可及性,避免因专利垄断导致药物价格高企。
(四)产业升级:资本驱动与生态构建的深度融合
产业资本与风险投资的介入,推动行业从技术驱动向资本+技术双轮驱动转型。药明康德为全球药企提供抗病毒药物一体化研发服务,浙江医药通过自建酶法合成生产线降低奥司他韦生产成本,体现产业链垂直整合趋势。
企业竞争策略从产品竞争转向生态竞争。某品牌推出"抗病毒口服液+健康课程"订阅服务,通过社群分享健康心得增强用户粘性。智能设备与家用检测仪的普及,实现预防-诊断-治疗-康复的闭环管理。这种生态化转型,正在重构抗病毒药物行业的价值创造模式。
抗病毒药物行业正处于技术革命与市场重构的历史交汇点。政策红利、技术创新与市场需求的共振,为行业带来前所未有的发展机遇。企业需以创新为矛、质量为盾、合作为桥,在研发端聚焦前沿技术,在生产端强化质量管控,在市场端深化全球布局。
对于投资者而言,基因疗法、AI制药、广谱抗病毒药物等细分领域蕴含巨大潜力。布局具有全产业链整合能力的龙头企业,或可分享行业增长红利。抗病毒药物的未来,不仅是技术的突破,更是人类与病毒博弈智慧的升华。在变革中把握机遇,在创新中引领发展,将成为行业参与者制胜未来的关键。
......
欲获悉更多关于行业重点数据及未来五年投资趋势预测,可点击查看中研普华产业院研究报告《2024-2029年抗病毒药行业风险投资态势及投融资策略指引报告》。

2024-2029年抗病毒药行业风险投资态势及投融资策略指引报告
风险投资是在创业企业发展初期投入风险资本,待其发育相对成熟后,通过市场退出机制将所投入的资本由股权形态转化为资金形态,以收回投资,取得高额风险收益。全球风险资本市场已进入新一轮快速...
查看详情 →
- 抗病毒药行业现状与发展趋势分析
- 2025年中国抗病毒药行业发展环境及前景分析
- 2024年抗病毒药行业发展环境、发展现状及壁垒分析
- 抗病毒药的主要类型、行业现状及市场发展分析
- 2024年抗病毒药行业市场发展现状及未来发展前景趋势分析
-

让决策更稳健 让投资更安全
-
掌握市场情报,就掌握主动权,扫码关注公众号,获取更多价值:
3000+ 细分行业研究报告 500+ 专家研究员决策智囊库 1000000+ 行业数据洞察市场 365+ 全球热点每日决策内参
-

中研普华
-

研究院

2025年中国水利建设行业发展现状分析及未来展望
中国水资源总量达2.8万亿立方米,但从人均水资源角度看,中国人均水资源占有量在全球排名第106位。在农业方面,中国亩均耕地水资源占有量约...

2026-2030年中国商业不动产REITs行业全景调研与发展趋势预测
商业不动产REITs试点迎来重大进展。近日,由中国证监会研究起草的《中国证监会关于推出商业不动产投资信托基金试点的公告(征求意见稿)》R...

天津市海洋经济行业“十五五”规划前景预测研究
中共天津市委关于制定天津市国民经济和社会发展第十五个五年规划的建议发布,其中提出,大力发展海洋经济。加强海洋科技创新,提高海洋能源...

2025-2030年中国PVDF行业全景调研与发展趋势预测分析
氟务在线数据显示,受成本端持续上行及企业协同挺价推动,PVDF企业预期报价已触及5.0万元/吨。11月25日,涂料级PVDF主流报价为4.7万~5.02...

2025-2030年中国人工智能行业全景调研与发展战略研究咨询分析
阿里巴巴发布2026财年第二季度财报,当季实现营收2478亿元,其中云智能集团收入398.2亿元,均超出市场预期,AI相关产品收入连续第九个季度A...

2025-2030年中国磷酸铁锂(LFP)行业全景评估与投资策略咨询
据媒体报道,由于我国磷酸铁锂行业陷入连续多年整体性亏损的窘境,产业无序竞争、低价内卷现象威胁全行业生存根基与持续发展大局,中国化学...
2025木瓜蛋白酶行业发展现状分析与未来展望

2025年中国手术器械行业:技术迭代与生态重构下的行业新格局

2025年基因检测行业:现状剖析、前景展望与趋势洞察

2025年医疗健康产业:技术驱动下的生态重构与价值跃迁

2025年负氧离子行业市场深度调研及投资战略研究

